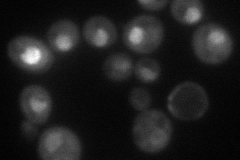
YLR421C
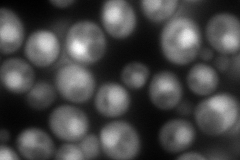
YLR421C
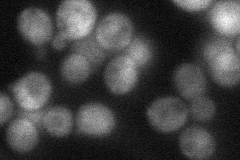
YLR421C
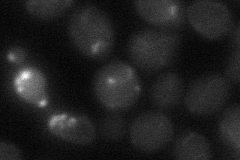
YLR421C
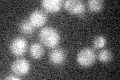
YLR421C

View description
Subunit of the 19S regulatory particle of the 26S proteasome lid; acts as a ubiquitin receptor for the proteasome; null mutants accumulate ubiquitinated Gcn4p and display decreased 26S proteasome stability
Localization:
Intensity:
Fold change:
Significance:
-
C’ GFP library in SD

below threshold16.29 -
N' NOP1pr-GFP in SD
nucleolus55.7446 -
N' TEF2pr-mCherry in SD
nucleus286.658 -
N' NATIVEpr-GFP in SD
nucleus41.1764 -
N' TEF2pr-VC and Cyto-VN in SD
below threshold24.4172 -
C’ GFP library in SD+DTT

cytosol15.940.97No -
C’ GFP library in SD+H2O2
cytosol15.990.98No -
C’ GFP library in Starvation Media

cytosol17.871.09No -
C’ GFP library on the background of Pup2-DaMP

below threshold -
C’ GFP library on the background of CCT mutant

below threshold16.55721.0159No
